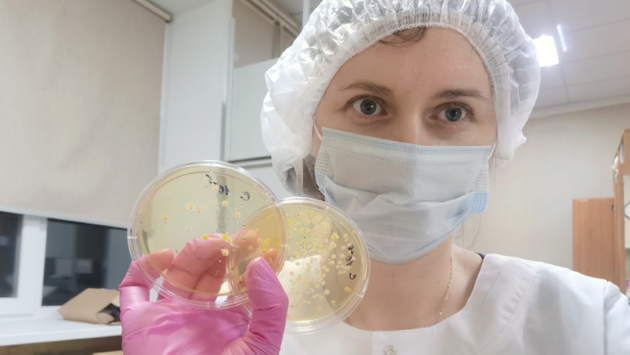

«Электронный нос» с высокой точностью оценил количество бактерий в продукте
Ученые создали датчик, который, подобно человеческому носу, улавливает летучие соединения, содержащиеся в молоке. Поскольку эти вещества появляются в продукте благодаря деятельности микроорганизмов, по их составу и количеству авторам с 83% точностью удалось оценить, какие именно бактерии содержатся в молоке и сколько их. Инструмент упростит оценку качества молочной продукции на производствах и поможет избежать распространения с молоком опасных для человека инфекций. Результаты исследования, поддержанного грантом Президентской программы Российского научного фонда (РНФ), опубликованы в журнале Sensors.
Один из критериев, по которым оценивают качество молока, — количество в нем микроорганизмов, в особенности патогенных, то есть тех, что могут вызвать у человека заболевания. К ним относятся сальмонеллы (Salmonella), поражающие желудочно-кишечный тракт, стафилококки (Staphylococcus), приводящие к воспалениям разных тканей и органов, и листерии (Listeria), инфицирующие нервную систему. Используемые на пищевых производствах методы микробиологического анализа трудозатратны и занимают несколько дней, поэтому ученые стремятся создать экспресс-системы для выявления опасных микроорганизмов в образцах молока.
Исследователи из Воронежского государственного университета инженерных технологий адаптировали пьезоэлектрический резонатор — устройство, преобразующее сигналы давления в электричество, — для оценки качества коровьего молока. Авторы нанесли на его рабочий элемент композитные пленки, чувствительные к летучим соединениям (фенолам, спиртам, органическим кислотам и другим веществам), которые содержатся в молоке. Эти молекулы появляются там благодаря жизнедеятельности различных микроорганизмов, поэтому по составу и количеству летучих соединений можно оценить, какие бактерии присутствуют в образце и насколько их много.
«Летучие соединения, образующиеся в молоке при наличии микроорганизмов, можно условно разделить на две группы: универсальные — те, что выделяются всеми видами бактерий, но в разных количествах, — и относительно специфичные для некоторых микроорганизмов. Сенсоры, подобно рецепторам в человеческом носу, фиксируют совокупность всех летучих соединений и по полученным данным с помощью математической модели рассчитывают количество бактерий в образце», — рассказывает руководитель проекта, поддержанного грантом РНФ, Анастасия Шуба, кандидат химических наук, доцент кафедры физической и аналитической химии Воронежского государственного университета инженерных технологий.
Для построения математической модели авторы сначала «обучили» сенсоры распознавать разные летучие вещества в определенных (заранее известных концентрациях) по отдельности, а затем сопоставлять их с соответствующими количествами микроорганизмов в молоке. Благодаря этому устройства «поняли», какое сочетание данных соответствует тому или иному числу бактерий в образце.
Авторы протестировали восемь сенсоров, чувствительных к разным летучим веществам, на 14 образцах сырого коровьего молока из пяти разных фермерских хозяйств. Для этого молоко полчаса выдерживали в герметичной емкости при комнатной температуре, после чего отбирали газовую фазу над молоком, в которой накапливались летучие соединения. Этот газ анализировали с помощью набора сенсоров. Ни в одной пробе патогенные бактерии не обнаружились, а общее число микроорганизмов варьировалось в широких диапазонах, согласно которым образцы можно было разделить на первый (три пробы) и второй сорт (четыре пробы), а также несортовое молоко.
После этого ученые определили во всех образцах количество и видовой состав бактерий с помощью стандартного микробиологического метода — посева на чашки Петри. Сравнение с этим подходом показало, что точность оценки числа микроорганизмов с помощью набора сенсоров составляет 83%. При этом предел определения кишечной палочки составил 100 бактерий на миллилитр молока, что считается границей нормы для готовых молочных продуктов.
«Предложенный инструмент может помочь сократить время, необходимое для анализа микробиологических показателей сырого молока. Это, в свою очередь, позволит своевременно принимать меры по сохранению качества продукции, предотвращать распространение инфекций и защищать здоровье населения. В дальнейшем мы будем пытаться повысить точность сенсоров, подробнее исследовав особенности выделения разных летучих соединений патогенными бактериями», — подводит итог Анастасия Шуба.